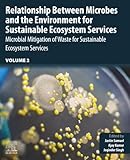
Amazon cover image

Relationship Between Microbes and Environment for Sustainable Ecosystem Services, Volume 2: Microbial Mitigation of Waste for Sustainable Ecosystem Services
Material type: TextLanguage: English Publication details: Elsevier Elsevier 2022ISBN:
TextLanguage: English Publication details: Elsevier Elsevier 2022ISBN: - 9780323899376
 eBooks
eBooks
| Item type | Current library | Home library | Status | Barcode | |
|---|---|---|---|---|---|
 eBooks
eBooks
|
Central Library | Central Library | Available | CL1720656 |
There are no comments on this title.
Log in to your account to post a comment.